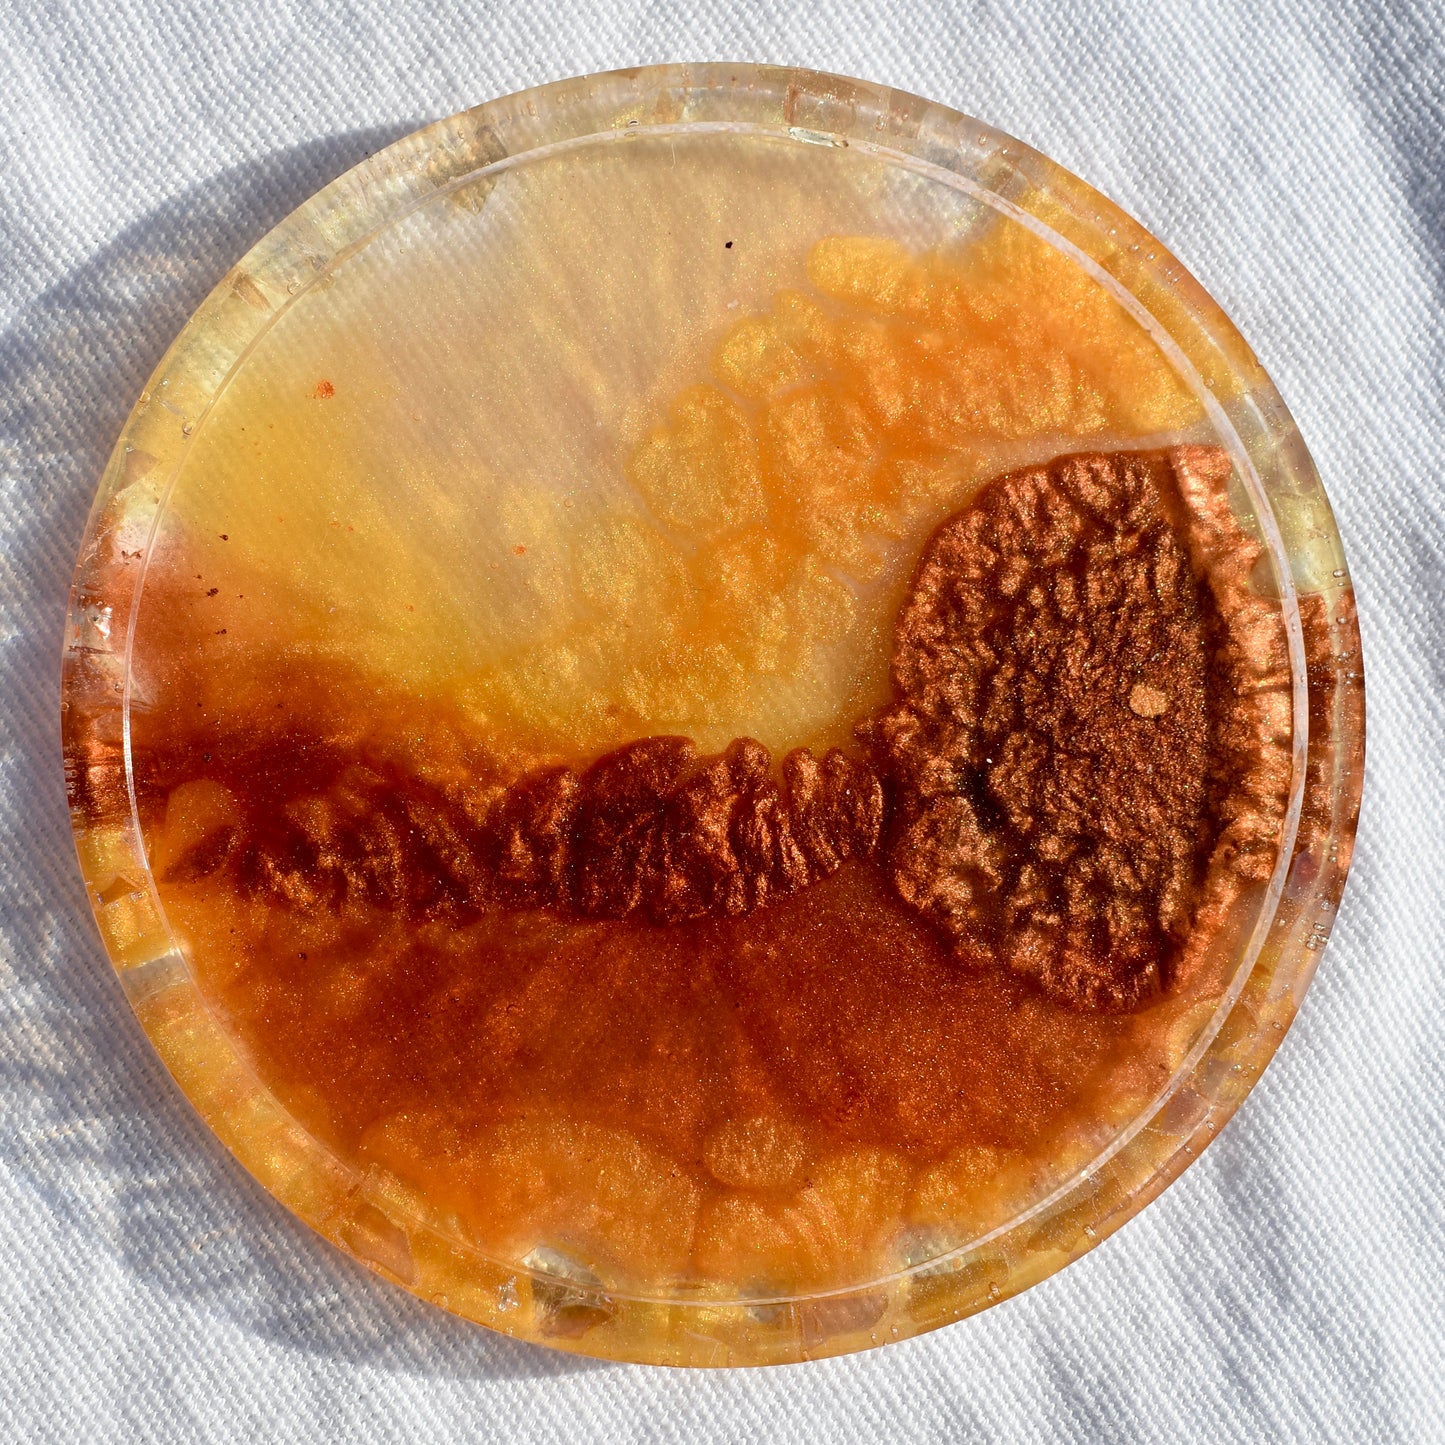
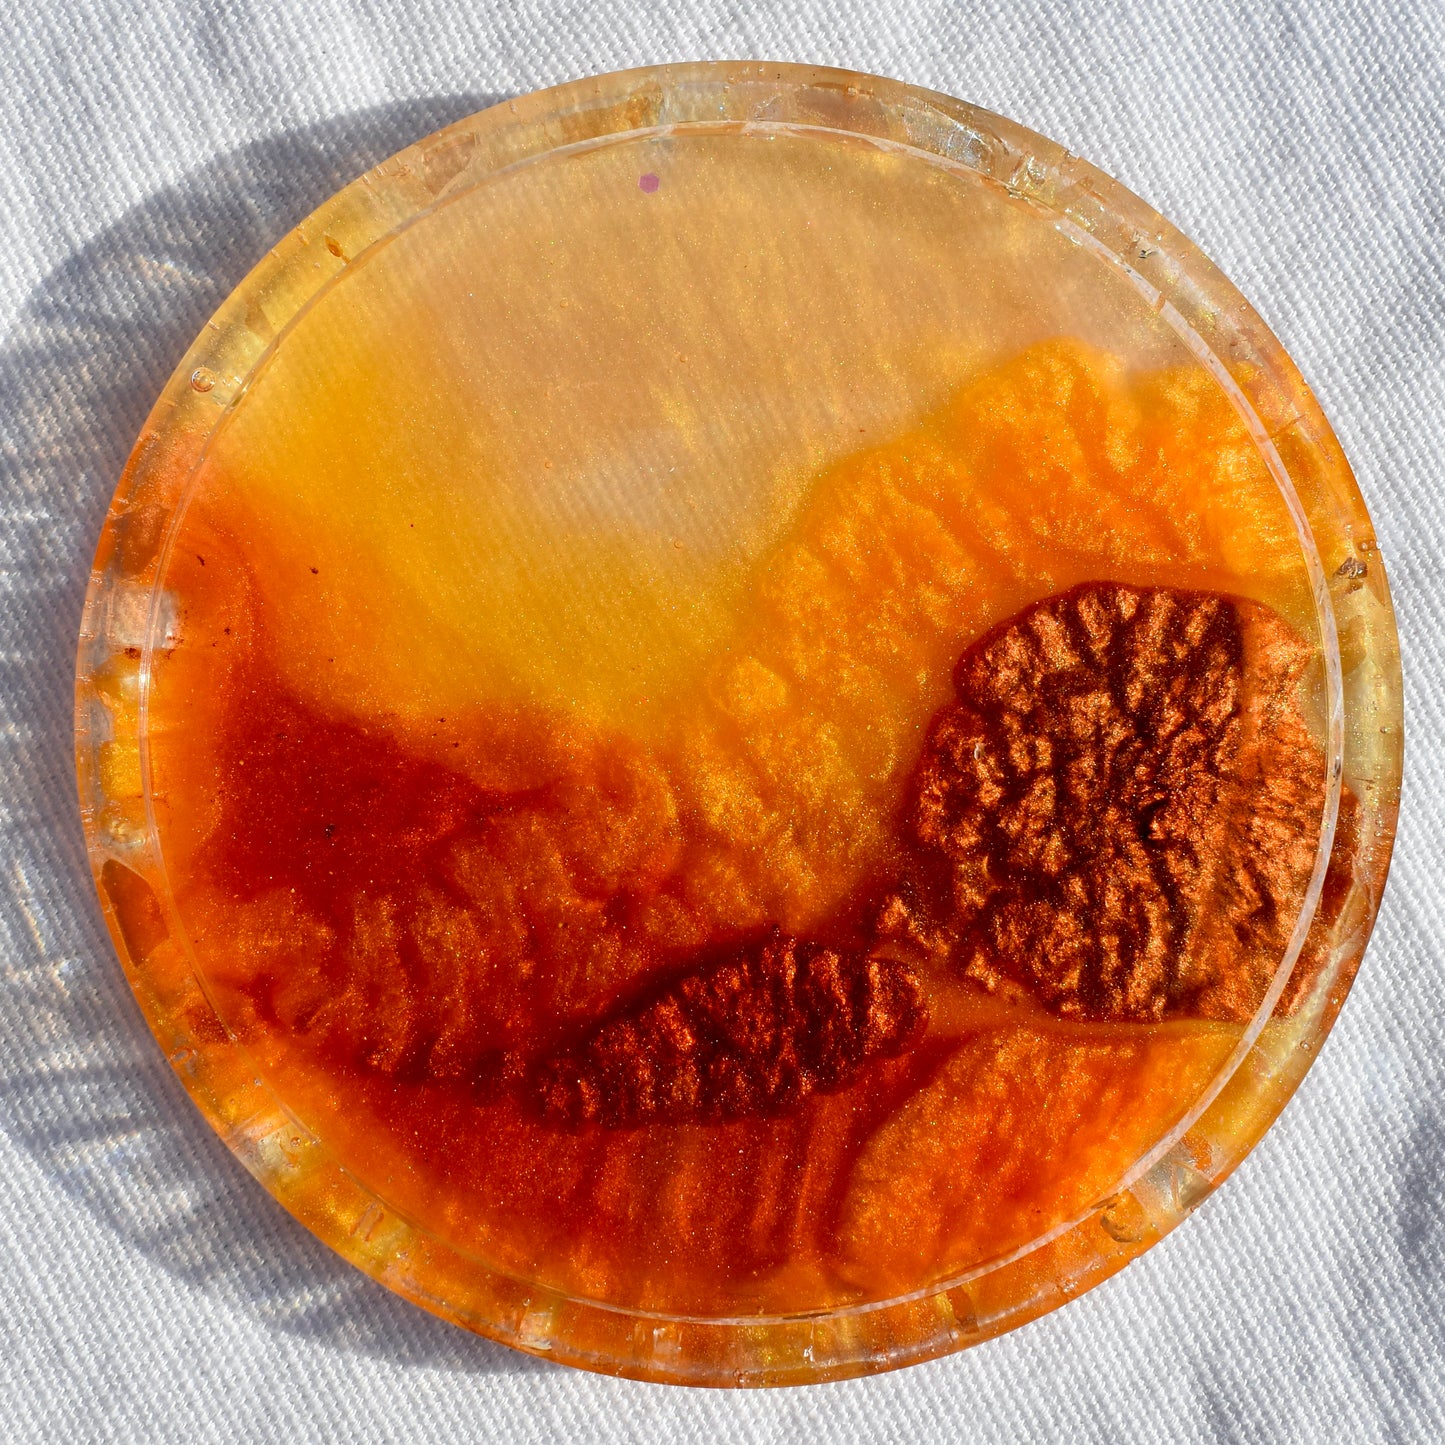
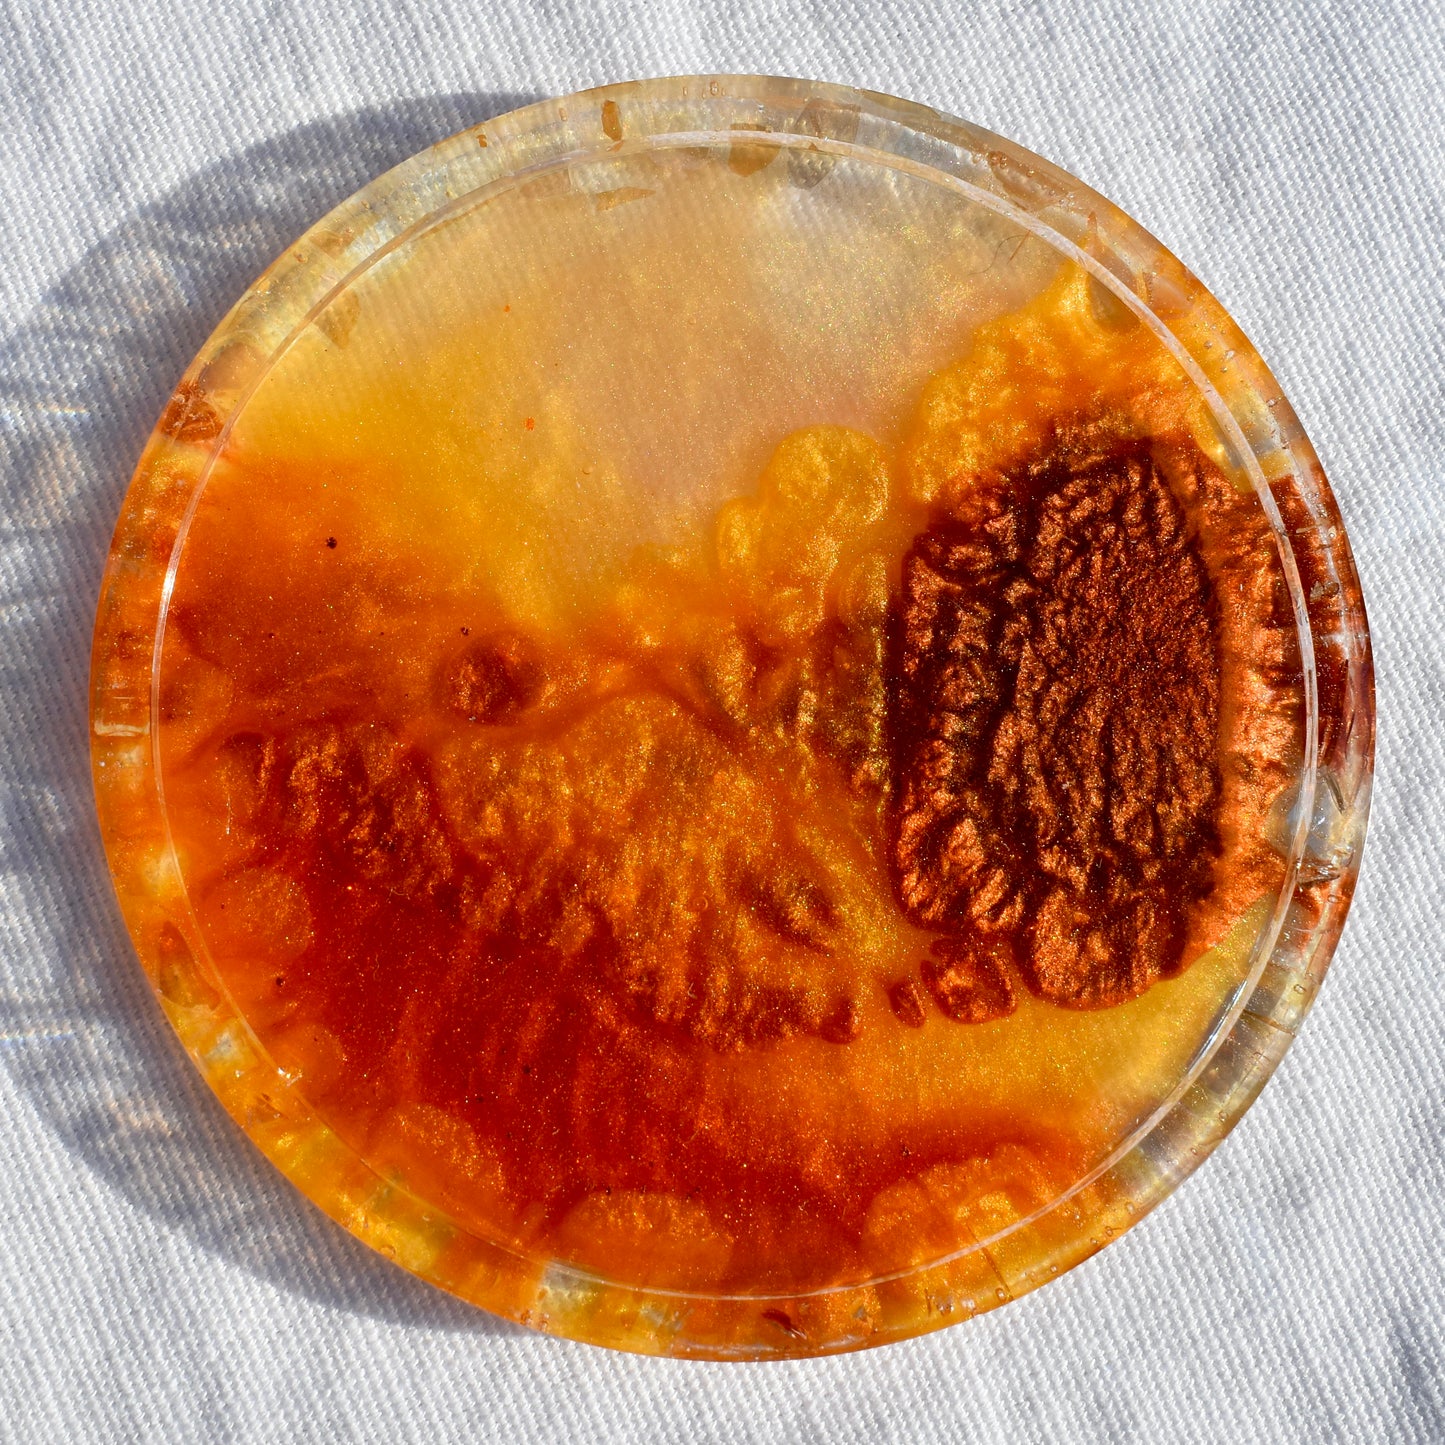

Sparrow Art Vibes
Fall Hues Coasters with Abalone Shells (Asst. Colors - set of 4)
Fall Hues Coasters with Abalone Shells (Asst. Colors - set of 4)
Couldn't load pickup availability
Beautify your table setting for family dinners or holiday gatherings with these autumn beverage coasters. Forget cliché pumpkin decor! Create the warmth of the fall season with these squash orange, copper, rich gold, chocolate brown, and fern green beverage coasters! These coasters will brighten any dining room table, coffee table, end table, or bar top! They feature a shimmery rim embellished with sparkling abalone shell flakes to catch any condensation so your table stays dry (no more puddles!) and your drinks are secure. This set will give your friends and guests something to talk about every time they pick up their drinks: sweet tea, lemonade, beer or cocktail. They fit any décor – formal, contemporary, or casual.
Purchase one of these sets or order a custom set in your choice of TWO colors.
WONDERFUL GIFT 🎁: Perfect gift for holiday dinner parties! Awesome gift for a friend, relative, birthday, housewarming, or any occasion. Great for any dining room, family room, home bar - any room that you want to add a touch of beauty. Buy a set for yourself! - You can ship our products directly to your gift recipient. We’d be happy to include a complimentary gift card. Please send us the text you’d like us to use in the notes to seller field.
SIZE:
-
4” round beverage coasters with rim (set of 4)
-
Proudly “handmade” in the USA!
-
Handcrafting process - Each coaster is unique
-
Created with resin to protect the integrity of the design
-
3M Bumpon™ rubber slip-resistant feet to protect furniture surface
PROCESSING TIME: - In stock items ship within 2 days. A personalized order takes 5 days to complete. It will ship after completion.
SHIPPING TIME: - 📦USPS can deliver most in-stock items within 3-5 business days.
CARE:
-
Easy maintenance
-
Clean coaster with soft damp cloth
-
Do not use any abrasive cleaners (will scratch surface)
-
Do NOT put in the dishwasher or leave sitting in water!
CUSTOM ORDERS: Do you need more than four coasters? I would be happy to create additional coasters for you! Please feel free to send me a direct message with your color palette. Processing time is 5 days.